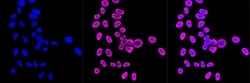
Invitrogen NME1 Recombinant Rabbit Monoclonal Antibody (23GB2180), Invitrogen

missing translation for 'onlineSavingsMsg'
Learn More
Learn More
Invitrogen™ NME1 Recombinant Rabbit Monoclonal Antibody (23GB2180), Invitrogen™
Rabbit Recombinant Monoclonal Antibody
Brand: Invitrogen™ MA553243
This item is not returnable.
View return policy
Description
NME1 was identified because of its reduced mRNA transcript levels in highly metastatic cells. Nucleoside diphosphate kinase (NDK) exists as a hexamer composed of 'A' (encoded by this gene) and 'B' (encoded by NME2) isoforms. Mutations in the gene have been identified in aggressive neuroblastomas. Two transcript variants encoding different isoforms have been found for this gene. Co-transcription of this gene and the neighboring downstream gene (NME2) generates naturally-occurring transcripts (NME1-NME2), which encodes a fusion protein comprised of sequence sharing identity with each individual gene product.
Specifications
| NME1 | |
| Recombinant Monoclonal | |
| Unconjugated | |
| NME1 | |
| AL024257; AWD; expressed in non-metastatic cells 1; expressed in non-metastatic cells 1 protein; expressed in non-metastatic cells 1 protein (NM23A) (nucleoside diphosphate kinase); expressed in non-metastatic cells 1, protein; expressed in non-metastatic cells 1, protein (NM23A) (nucleoside diphosphate kinase); GAAD; Granzyme A activated DNase (GAAD); Granzyme A-activated DNase; GZMA activated DNase; included; metastasis inhibition factor NM23; NB; NBR-A; NBR-B; NBS; NDK A; NDK A 1; NDK A 2; NDK NBR-A; NDK NBR-B; NDKA; NDP kinase A; NDP kinase A 1; NDP kinase A 2; NDP kinase beta; NDP kinase NBR-A; NDPKA; NDPK-A; NM23; NM23A; NM23-C1; NM23-H1; NM23H1B; nm23-M1; NME/NM23 nucleoside diphosphate kinase 1; Nme1; NME1-1; NME1-NME2 spliced read-through transcript; non-metastatic cells 1, protein (NM23A) expressed in; nucleoside diphosphate kinase A; nucleoside diphosphate kinase A 1; nucleoside diphosphate kinase A 2; nucleoside diphosphate kinase NBR-B; nucleoside-diphosphate kinase 1; nucleoside-diphosphate kinase NBR-A; nucleotide diphosphate kinase; nucloside diphosphate kinase; tumor metastatic process-associated protein | |
| Rabbit | |
| Affinity chromatography | |
| RUO | |
| 4830 | |
| -20°C | |
| Liquid |
| Western Blot, Immunocytochemistry | |
| 23GB2180 | |
| PBS with 50% glycerol and 0.02% sodium azide; pH 7.4 | |
| P15531 | |
| NME1 | |
| A synthesized peptide derived from human NM23A (1-50AA). | |
| 20 μL | |
| Primary | |
| Human | |
| Antibody | |
| IgG |
Product Content Correction
Your input is important to us. Please complete this form to provide feedback related to the content on this product.
Product Title
Spot an opportunity for improvement?Share a Content Correction